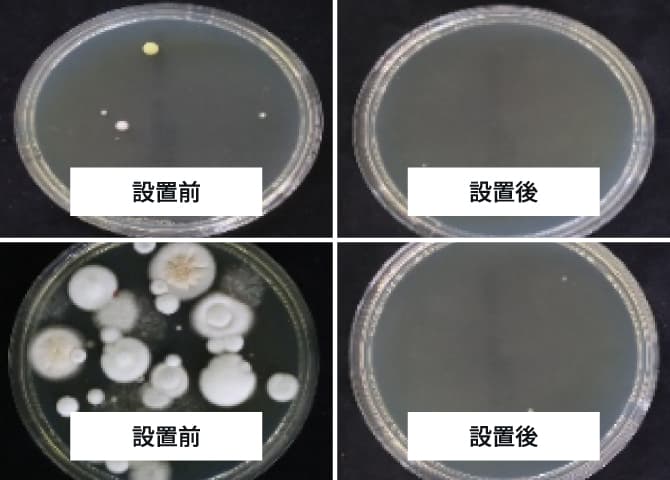
導入事例

Products
取扱い商品

ステリルキーパー
Steril Keeper
ユニットクーラー内部の空気を清潔に保つ、UVC殺菌ユニット
Point.01
ユニットクーラー内部を殺菌し、より安心・安全な環境を実現。
ユニットクーラーの熱交換器部に、空調専用の「高出力紫外線殺菌灯」を直接照射。カビ菌・バクテリアなどの微生物をDNAレベルで破壊・不活性化し、内部を清潔に保ちます。また、薬剤などを使用しないため、より安心・安全な環境を実現します。

Point.02
汚れや詰まりの原因を抑制し、清掃コストの低減&省エネ化。
微生物の発生を抑えることで、内部機器の清掃・メンテナンスにかかるコストを低減。また、コイル目詰まりの解消により、導入当初の冷却能力へと回復させ、最大約20%の省エネ効果を実現します。

Point.03
既存のユニットクーラーに装着可能で、さまざまな環境を清潔に。
「Steril Keeper」は、既存のユニットクーラーに装着することが可能。設備を新しくしたり、大がかりな工事をすることなく、カビやバクテリアでお困りの環境を改善します。


高出力紫外線殺菌灯UVC-
EMITTER® UVCエミッター
「UVC-EMITTER(UVCエミッター)」は高出力の紫外線で、健康被害や汚れ、においの原因となるウイルス・細菌・カビなどの微生物を殺菌。繁殖を抑えることで、長く使える空調設備を実現し、安心・安全・快適な環境を提供します。
Case
導入事例
さまざまな企業さまに導入いただき、
効果を実感いただいています。